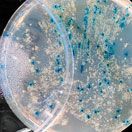

The performance of nanoparticles used as carriers in drug delivery is intimately linked to their physical properties. Nanoprecipitation is a common method for the preparation of drug-loaded polymer nanoparticles, but until recently, the reproducibility of the two primary dimensional descriptors-the average particle size and the breadth of the size distribution-has been a challenge due to the intrinsic variability of batch processes. Microfluidics-based flow techniques, however, reduce variation in drug-loaded polymer nanoparticle synthesis.